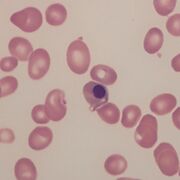
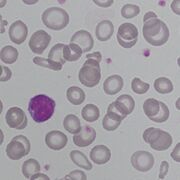
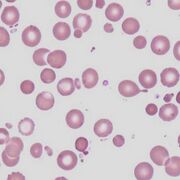
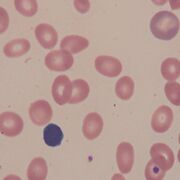
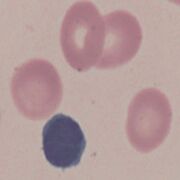
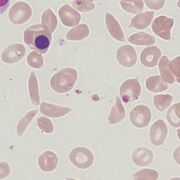
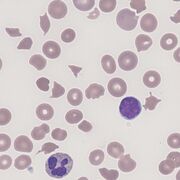
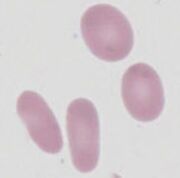

Uploads by John
This special page shows all uploaded files.
| Date | Name | Thumbnail | Size | Description | Versions |
|---|---|---|---|---|---|
| 13:43, 22 March 2023 | Ova1.png (file) |  |
83 KB | 1 | |
| 12:23, 21 March 2023 | Nrbc5.jpg (file) |  |
58 KB | 1 | |
| 12:23, 21 March 2023 | Nrbc4.jpg (file) |  |
36 KB | 1 | |
| 12:23, 21 March 2023 | Nrbc3.jpg (file) | |
32 KB | 1 | |
| 12:23, 21 March 2023 | Nrbc 2.jpg (file) |  |
25 KB | 1 | |
| 12:22, 21 March 2023 | Nrbc1.png (file) |  |
103 KB | 1 | |
| 17:44, 20 March 2023 | HypoC5.jpg (file) |  |
60 KB | 1 | |
| 17:43, 20 March 2023 | HypoC4.jpg (file) | |
50 KB | 1 | |
| 17:43, 20 March 2023 | HypoC3.jpg (file) |  |
42 KB | 1 | |
| 17:43, 20 March 2023 | HypoC2.jpg (file) |  |
32 KB | 1 | |
| 17:43, 20 March 2023 | HypoC1.png (file) |  |
158 KB | 1 | |
| 16:35, 19 March 2023 | MSp5.jpg (file) |  |
142 KB | 1 | |
| 16:35, 19 March 2023 | MSp4.jpg (file) |  |
41 KB | 1 | |
| 16:34, 19 March 2023 | MSp3.JPG (file) | |
42 KB | 1 | |
| 16:34, 19 March 2023 | MSp2.jpg (file) |  |
27 KB | 1 | |
| 16:34, 19 March 2023 | MSp1.png (file) |  |
78 KB | 1 | |
| 16:08, 19 March 2023 | Mac4.jpg (file) |  |
43 KB | 1 | |
| 16:07, 19 March 2023 | Mac3.jpg (file) | |
42 KB | 1 | |
| 16:07, 19 March 2023 | Mac2.jpg (file) | |
32 KB | 1 | |
| 16:07, 19 March 2023 | Mac1.png (file) |  |
150 KB | 1 | |
| 15:58, 19 March 2023 | IRC5.jpg (file) |  |
65 KB | 1 | |
| 15:58, 19 March 2023 | IRC4.jpg (file) | |
54 KB | 1 | |
| 15:57, 19 March 2023 | IRC3.jpg (file) |  |
61 KB | 1 | |
| 15:57, 19 March 2023 | IRC2.jpg (file) |  |
30 KB | 1 | |
| 15:57, 19 March 2023 | IRC1.png (file) |  |
71 KB | 1 | |
| 15:45, 19 March 2023 | HJ5.jpg (file) |  |
49 KB | 1 | |
| 15:45, 19 March 2023 | HJ4.jpg (file) |  |
67 KB | 1 | |
| 15:45, 19 March 2023 | HJ3.jpg (file) |  |
58 KB | 1 | |
| 15:44, 19 March 2023 | HJ2.jpg (file) |  |
32 KB | 1 | |
| 15:44, 19 March 2023 | HJ1.png (file) |  |
87 KB | 1 | |
| 10:58, 14 March 2023 | Crys6.jpg (file) |  |
66 KB | 1 | |
| 10:58, 14 March 2023 | Crys5.jpg (file) |  |
65 KB | 1 | |
| 10:58, 14 March 2023 | Crys4.jpg (file) |  |
59 KB | 1 | |
| 10:57, 14 March 2023 | Crys3.jpg (file) |  |
67 KB | 1 | |
| 10:57, 14 March 2023 | Crys2.jpg (file) |  |
27 KB | 1 | |
| 10:57, 14 March 2023 | Crys1.png (file) |  |
63 KB | 1 | |
| 10:45, 14 March 2023 | Fr8.jpg (file) |  |
89 KB | 1 | |
| 10:45, 14 March 2023 | Fr7.jpg (file) |  |
99 KB | 1 | |
| 10:44, 14 March 2023 | Fr6.jpg (file) | |
79 KB | 1 | |
| 10:44, 14 March 2023 | Fr5.jpg (file) |  |
78 KB | 1 | |
| 10:43, 14 March 2023 | Fr4.jpg (file) |  |
43 KB | 1 | |
| 10:43, 14 March 2023 | Fr3.png (file) |  |
57 KB | 1 | |
| 10:43, 14 March 2023 | Fr2.jpg (file) |  |
39 KB | 1 | |
| 10:42, 14 March 2023 | Fr1.png (file) |  |
68 KB | 1 | |
| 11:09, 13 March 2023 | Ellip4.jpg (file) |  |
58 KB | 1 | |
| 11:02, 13 March 2023 | Ellip6.jpg (file) |  |
59 KB | 1 | |
| 11:02, 13 March 2023 | Ellip5.jpg (file) |  |
59 KB | 1 | |
| 11:02, 13 March 2023 | Ellip4.JPG (file) |  |
58 KB | 1 | |
| 11:01, 13 March 2023 | Ellip3.jpg (file) |  |
50 KB | 1 | |
| 11:01, 13 March 2023 | Ellip2.jpg (file) | |
26 KB | 1 |